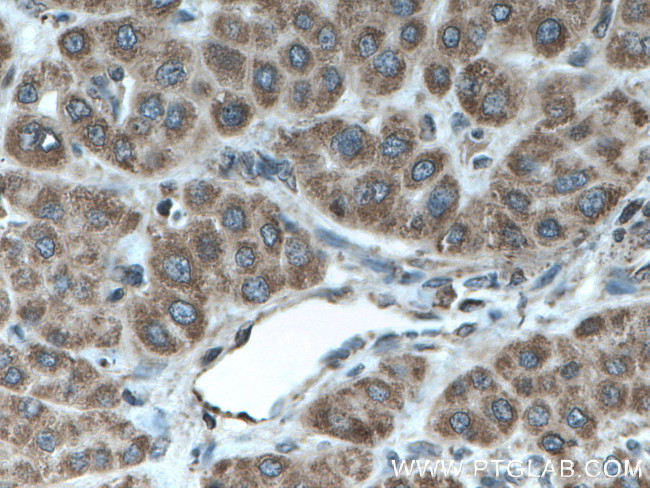
TAPT1 Antibody in Immunohistochemistry (Paraffin) (IHC (P))
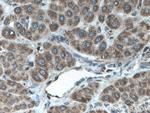
TAPT1 Antibody in Immunohistochemistry (Paraffin) (IHC (P))

Search
Proteintech
TAPT1 Polyclonal Antibody
{{$productOrderCtrl.translations['antibody.pdp.commerceCard.promotion.promotions']}}
{{$productOrderCtrl.translations['antibody.pdp.commerceCard.promotion.viewpromo']}}
{{$productOrderCtrl.translations['antibody.pdp.commerceCard.promotion.promocode']}}: {{promo.promoCode}} {{promo.promoTitle}} {{promo.promoDescription}}. {{$productOrderCtrl.translations['antibody.pdp.commerceCard.promotion.learnmore']}}
产品信息
27657-1-AP
种属反应
宿主/亚型
分类
类型
抗原
偶联物
形式
浓度
规格
纯化类型
保存液
内含物
保存条件
运输条件
产品详细信息
Immunogen sequence: MVQATTLNV AFNSHNKSLL TIMMSNNFVE IKGSVFKKFE KNNLFQMSNS DIKERFTNYV LLLIVCLRNM EQFSWNPDHL WVLFPDVCMV IASEIAVDIV KHAFITKFND ITADVYSEYR ASLAFDLVSS RQKNAYTDYS DSVARRM (257-402 aa encoded by BC066899 )
靶标信息
This gene encodes a highly conserved, putative transmembrane protein. A mutation in the mouse ortholog of this gene results in homeotic, posterior-to-anterior transformations of the axial skeleton which are similar to the phenotype of mouse homeobox C8 gene mutants. This gene is proposed to function downstream of homeobox C8 to transduce extracellular patterning information during axial skeleton development. An alternatively spliced transcript variant encoding a substantially different isoform has been described, but its biological validity has not been determined.
仅用于科研。不用于诊断过程。未经明确授权不得转售。
生物信息学
蛋白别名: Cytomegalovirus partial fusion receptor; Transmembrane anterior posterior transformation protein 1; Transmembrane anterior posterior transformation protein 1 homolog; unnamed protein product
基因别名: 4932414K18Rik; CMVFR; OCLSBG; TAPT1
UniProt ID: (Human) Q6NXT6, (Mouse) Q4VBD2
Entrez Gene ID: (Human) 202018, (Mouse) 231225